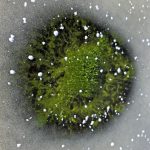
Zelený led na Lipně: Sinice překvapily uprostřed zimy

Zelený led na Lipně: Sinice překvapily uprostřed zimy

LIPNO – Neobvyklý přírodní jev se objevil na jihočeské nádrži Lipno na konci roku 2025. Velké množství nahromaděných sinic ve vodě způsobilo zelené zbarvení ledu. Úkaz podrobně zdokumentovali hydrobiologové z Biologického centra Akademie věd ČR, kteří provedli i odběry a analýzy vzorků. Vzhledem k tomu, že existuje velmi málo vědeckých záznamů tohoto jevu, bude lipenský zelený led jedním z nejlépe popsaných případů na světě.
Fenomén potvrzuje, že lipenská nádrž je dlouhodobě zatížená nadbytkem živin ve vodě, takzvanou eutrofizací, zároveň je ovlivňována oteplováním klimatu a změny v jejím ekosystému tak probíhají i mimo tradiční letní sezonu. Mikroskopická analýza odebraných vzorků potvrdila, že se jednalo o běžnou sinici Woronichinia naegeliana, která na Lipně převládá i během léta a podzimu.
Základní příčinou rozvoje sinic je nadbytek živin ve vodě, především fosforu, který je z velké části důsledkem lidské činnosti. Zatímco na většině českých přehrad vodní květy sinic s příchodem podzimu postupně mizí a zpravidla se vytrácejí koncem září, Lipno je v tomto ohledu výjimkou. Dlouhodobá data ukazují, že sinice zde často převládají až do listopadu a v menším množství se mohou vyskytovat i během prosince a ledna.
V závěru roku 2025 se biomasa sinic držela u hladiny nezvykle dlouho, od podzimu až do zimního zamrznutí nádrže, a to zřejmě díky kombinaci klidného počasí, slabého větru a dlouhé délce slunečního svitu. Pod tenkou a místy velmi průhlednou ledovou pokrývkou tak nahromaděné sinice vytvářely nápadné zelené plochy viditelné ze břehu i z leteckých snímků.
Nejvíce patrný byl zelený led v období přechodného oteplení okolo Štědrého dne, po opětovném zamrznutí byla zvlášť výrazným rysem takzvaná sinicová oka, tedy místa s čirým ledem nad tmavými shluky sinic, která vznikla rozdílným pohlcováním slunečního záření. Fenomén přetrval až do konce roku a pravděpodobně skončil až po vydatném sněžení, které omezilo přístup světla pod led.
„Zelený led na Lipně zapadá do dlouhodobých změn, které zde pozorujeme v souvislosti s eutrofizací i probíhající změnou klimatu. Naznačuje, že podobných překvapení můžeme být v budoucnu svědky stále častěji,“ říká hydrobiolog Petr Znachor z Biologického centra Akademie věd ČR. Podledový výskyt sinic je ve světě vzácný a dosud byl zdokumentován jen v malém počtu případů. Nynější pozorování na Lipně tak patří mezi nejlépe popsané záznamy a zároveň ukazuje, že i běžné druhy sinic mohou za určitých podmínek vykazovat netypické chování.
Daniela Procházková



Diskuse k článku